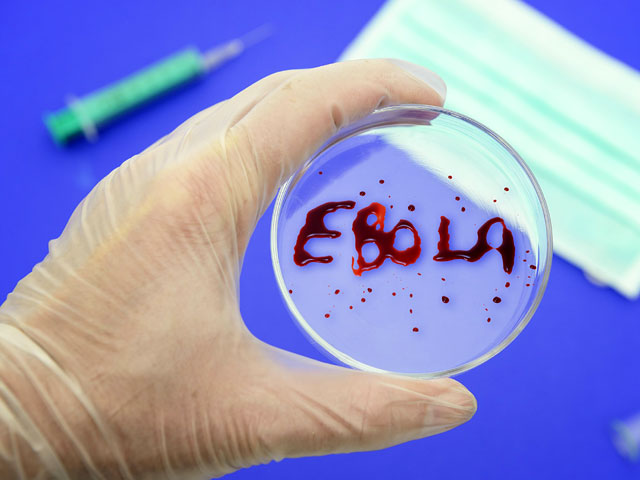

Вирус Эбола угрожает существованию Либерии, заявил министр обороны страны Совбезу ООН
Министр обороны Либерии заявил на заседании Совбеза ООН во вторник, 9 сентября, что эпидемия вируса Эбола ставит под угрозу само существование его государства, а также обвинил международное сообщество в недостаточной помощи, передает BBC. На данный момент число погибших составляет почти 2300 человек, причем половина смертей приходится на последние три недели, утверждают во Всемирной организации здравоохранения (ВОЗ).
По словам Самукая, Либерия не располагает "достаточной инфраструктурой, возможностями в логистике, а также финансовыми ресурсами и профессионалами, чтобы противостоять болезни".
Представитель ООН в Либерии заявил, что вирусом заразились как минимум 160 медиков, половина из них скончалась. Напомним, в начале сентября медсестры Либерии начали забастовку, требуя повысить зарплату и обеспечить персонал средствами защиты от вируса.
В отличие от других западно-африканских стран, в Либерии меры, направленные на сдерживание заболевания, не сработали. Ученые не могут назвать точную причину этого, однако полагают, что эпидемии способствуют похоронные традиции, которые включают прикосновение к телу умершего и обязательную трапезу в непосредственной близости от него.
Кроме того, в больницах не хватает коек, поэтому многих заболевших отправляют домой, где они продолжают распространять инфекцию.
Эксперты ВОЗ считают, что мировое сообщество должно в 3-4 раза увеличить помощь Африке. Ранее сообщалось, что организация подсчитала - на борьбу с вирусом нужны полмиллиарда долларов.
Между тем российское Министерство обороны принимает меры для защиты военных, выезжающих в страны Африки, пишет "Интерфакс".
"Для военнослужащих, выезжающих в страны Африки, введены обязательные профилактические инструктажи по санитарно-эпидемиологической обстановке, симптомам лихорадки Эбола, мерам личной профилактики, порядку использования средств индивидуальной защиты, действиям в случае заболевания", - сказано в сообщении пресс-службы Центрального военного округа (ЦВО).
Штаб округа также сообщает о создании запасов медикаментов, средств индивидуальной защиты, дезинфектантов и специального оборудования. Кроме того, в готовность приведена подвижная санитарно-эпидемиологическая группа.
В воинских коллективах организованы медосмотры и усиленное трехнедельное наблюдение - именно столько может длиться инкубационный период вируса Эбола. Ранее Минобороны сообщало, что берет на особый контроль тысячу военнослужащих, которые возвращаются из Африки.